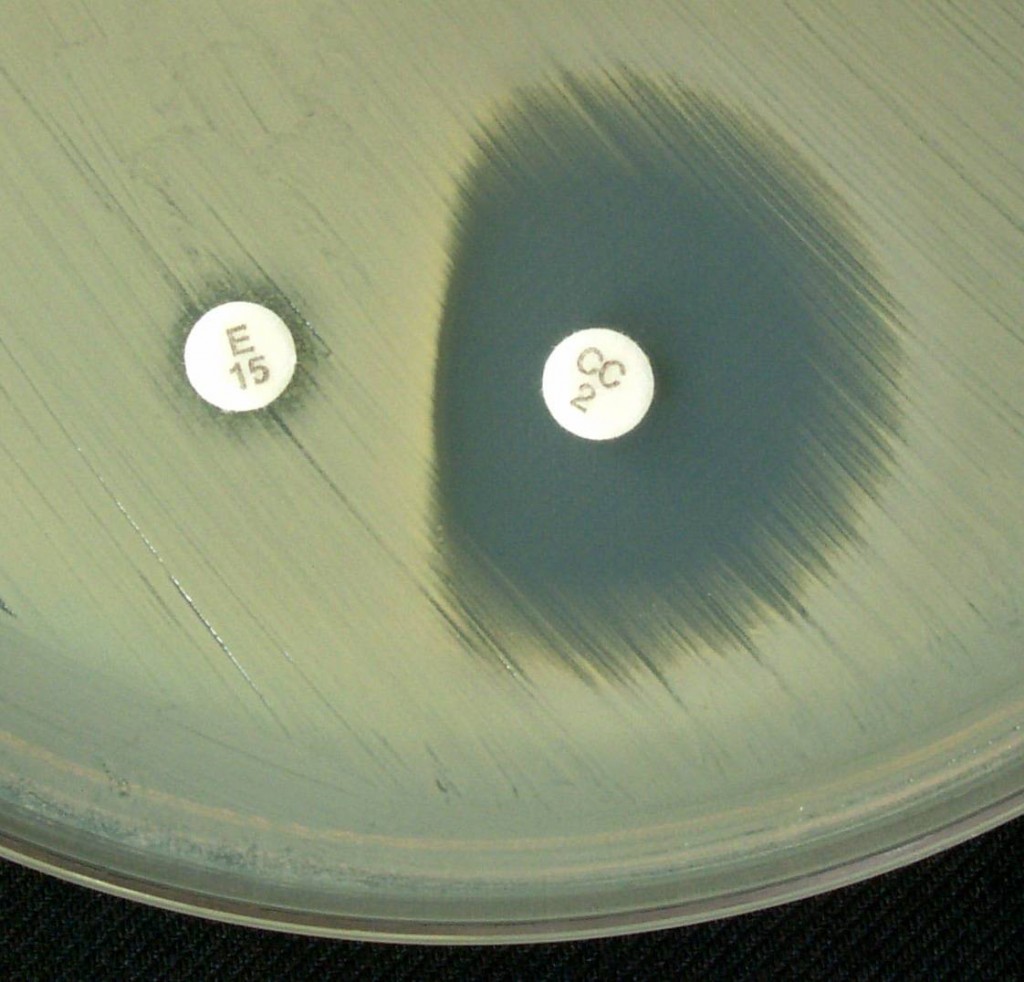
Inducible Clindamycin Resistance - Positive Inducible Clindamycin Resistance (D-test) test

Inducible clindamycin resistance in staphylococci and streptococci can be detected by the disk diffusion method using clindamycin and erythromycin disks or broth microdilution methods. D-zone test is described in this post.
The CLSI recommends testing for inducible clindamycin resistance in all staphylococci, Streptococcus pneumoniae, and beta-hemolytic streptococci that are erythromycin-resistant and clindamycin susceptible or intermediate prior to reporting clindamycin results.
Principle
D-zone test is performed by disk diffusion, placing a 15-μg erythromycin disk in proximity to a 2-μg clindamycin disk on an agar plate that has been inoculated with a staphylococcal or streptococcal isolate; the plate is then incubated overnight.
A flattening of the zone of inhibition around the clindamycin disk proximal to the erythromycin disk (producing a zone of inhibition shaped like the letter D) is considered a positive result and indicates that the erythromycin has induced clindamycin resistance (a positive “D-zone test”).
For erythromycin-resistant isolates, induction tests can help laboratories determine whether results for clindamycin should be reported as susceptible (when the induction test is negative) or as resistant (when the induction test is positive).
Mechanism of Action of Erythromycin and Clindamycin and Development of Resistance
Erythromycin (a macrolide) and clindamycin (a lincosamide) represent two distinct classes of antimicrobial agents that inhibit protein synthesis by binding to the 50S ribosomal subunits of bacterial cells. In staphylococci, resistance to both of these antimicrobial agents can occur through methylation of their ribosomal target site. Such resistance is typically mediated by erm genes.
Clinical significance of Inducible Clindamycin resistance
Macrolide-lincosamide-streptogramin B (MLSB) resistance, which is mediated by target side modification mechanism, results in resistance to erythromycin, clindamycin, and streptogramin B. This mechanism can be
- Constitutive, where the rRNA methylase is always produced, If In vitro testing is done Staphylococcus aureus isolates with constitutive resistance are resistant to erythromycin and clindamycin.
- Or can be inducible, where methylase is produced only in the presence of an inducing agent (Note: erythromycin is an effective inducer of macrolide-lincosamide-streptogramin B (MLSB) resistance). Isolates with inducible resistance are resistant to erythromycin but appear susceptible to clindamycin in routine in-vitro testing).
Clinical Significance of D Test
Clindamycin is an attractive agent for empirical therapy for suspectedS. aureus infections because of its excellent pharmacokinetic and pharmacodynamic properties. Clinical failures of clindamycin therapy for the treatment of MRSA infections have been documented for strains that were clindamycin sensitive but erythromycin resistant. The failures were due to inducible resistance to clindamycin.
In such cases, In vivo, therapy with Clindamycin may select for constitutive erm mutants, which may lead to clinical failure. Clindamycin resistance may be constitutive or inducible. Routine antibiotic susceptibility tests cannot identify these strains. The D (inducible clindamycin resistance) test is employed to detect inducible clindamycin resistance.
Procedure for D-zone Test
- Prepare 0.5 McFarland standard suspension of erythromycin-resistant Staphylococcus aureus isolates using either direct colony suspension or log-phase method of inoculum preparation.
- Make a lawn culture of bacteria in agar plates and allow it to stand for 3 to 15 min.
Mueller-Hinton agar (MHA) for staphylococci MHA with 5% sheep blood or TSA supplemented with 5% sheep blood for streptococci
- Put clindamycin (2-μg ) and erythromycin (15-μg ) disks approximately 15 mm apart (measured edge to edge). For beta-hemolytic streptococci and S. pneumoniae, place disks 12 mm apart.
- Invert plates and incubate the plate for 16 to 18 hours at 35°C.
Incubate staphylococci for 16 to 18 h at 35°C in an ambient-air incubator. Incubate beta-hemolytic streptococci and S. pneumoniae for 20 to 24 h at 35°C in 5% CO2 incubator.
Interpretationand Reporting
- Inducible clindamycin resistance = flattening of the zone of inhibition adjacent to the erythromycin disk (D-zone)
- No inducible clindamycin resistance = completely round zone of inhibition around clindamycin disk
- Hazy growth within the zone of inhibition around the clindamycin disk indicates clindamycin resistance, even if no D-zone is apparent.
Inducible clindamycin-resistant isolates should be reported as clindamycin-resistant alongside a comment stating that inducible clindamycin resistance is in vitro results and clindamycin may still be effective in some patients.
Limitations
- Despite positive results for inducible clindamycin resistance, clindamycin may still be effective in some patients.
- The D-zone test is only standardized to detect inducible clindamycin resistance for Staphylococcusspp., S.pneumoniae, and beta-hemolytic Streptococcus.
- Strict adherence to protocol is required to ensure reliable results as numerous factors such as inoculum size, rate of growth, pH and formulation of media, incubation condition and duration, disk content, etc can affect the result.
References
- Kishk, R. M., Anani, M. M., Nemr, N. A., Soliman, N. M., & Fouad, M. M. (2020). Inducible clindamycin resistance in clinical isolates of staphylococcus aureus in Suez Canal University Hospital, Ismailia, Egypt. Journal of infection in developing countries, 14(11), 1281–1287. https://doi.org/10.3855/jidc.12250
- Prabhu, K., Rao, S., & Rao, V. (2011). Inducible Clindamycin Resistance in Staphylococcus aureus Isolated from Clinical Samples. Journal of laboratory physicians, 3(1), 25–27. https://doi.org/10.4103/0974-2727.78558